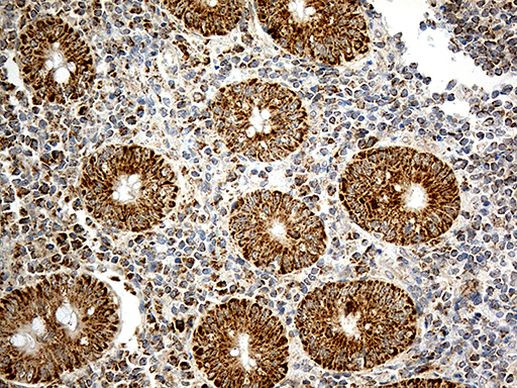
ATP5I Antibody in Immunohistochemistry (Paraffin) (IHC (P))
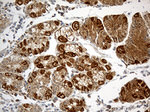
ATP5I Antibody in Immunohistochemistry (Paraffin) (IHC (P))

Search
OriGene
ATP5I Monoclonal Antibody (OTI1E6), TrueMAB™
{{$productOrderCtrl.translations['antibody.pdp.commerceCard.promotion.promotions']}}
{{$productOrderCtrl.translations['antibody.pdp.commerceCard.promotion.viewpromo']}}
{{$productOrderCtrl.translations['antibody.pdp.commerceCard.promotion.promocode']}}: {{promo.promoCode}} {{promo.promoTitle}} {{promo.promoDescription}}. {{$productOrderCtrl.translations['antibody.pdp.commerceCard.promotion.learnmore']}}
产品信息
TA811780
种属反应
宿主/亚型
分类
类型
克隆号
抗原
偶联物
形式
浓度
规格
纯化类型
保存液
内含物
保存条件
运输条件
靶标信息
Mitochondrial ATP synthases (ATPases) transduce the energy contained in membrane electrochemical proton gradients into the energy required for synthesis of high-energy phosphate bonds. ATPases contain two linked complexes: F1, the hydrophilic catalytic core; and F0, the membrane-embedded protein channel. The two complexes are linked by a central stalk and a peripheral stalk. During catalysis, ATP synthesis in the catalytic domain of F1 is coupled, via a rotary mechanism of the central stalk subunits, with proton translocation across the membrane. ATP5I, also known as mitochondrial ATP synthase subunit E or ATP5K, is a 69 amino acid protein member of the ATPase E subunit family. Localized to the inner membrane of the mitochondria, ATP5I is a part of the F0 complex.
仅用于科研。不用于诊断过程。未经明确授权不得转售。
篇参考文献 (0)
生物信息学
蛋白别名: ATP synthase e chain, mitochondrial; ATP synthase F(0) complex subunit e, mitochondrial; ATP synthase membrane subunit e; ATP synthase subunit e, mitochondrial; ATP synthase, H+ transporting, mitochondrial F0 complex, subunit E; ATP synthase, H+ transporting, mitochondrial Fo complex subunit E; ATPase subunit e; F1F0-ATP synthase, murine e subunit
基因别名: ATP5I; ATP5K; ATP5ME
UniProt ID: (Human) P56385
Entrez Gene ID: (Human) 521